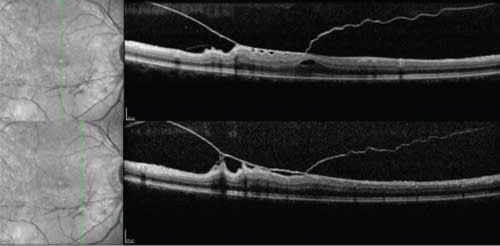
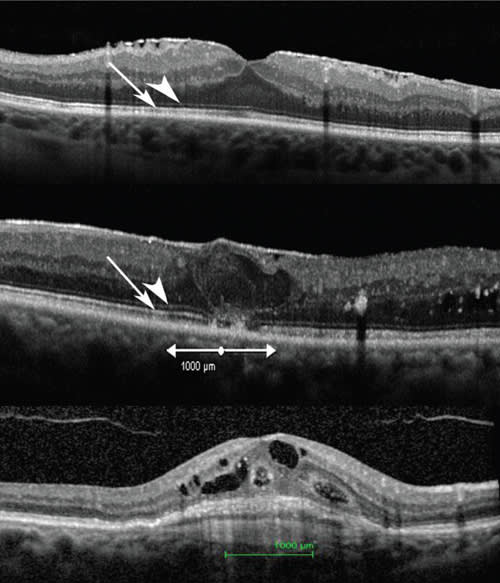

The Role of Predictors of Success in Managing Vitreomacular Adhesions
SD-OCT represents a major advance in understanding VMA.
Jay Chhablani, MD • William R. Freeman, MD
Vitreomacular adhesion (VMA) is defined as adhesion of the posterior hyaloid cortex involving the macular region. VMA plays a major role in the development of diseases, such as vitreomacular traction syndrome (VMTS), macular holes, epiretinal membrane (ERM), tractional macular edema, and myopic macular retinoschisis. In addition, the role of vitreomacular adhesions has been proposed in diabetic macular edema and age-related macular degeneration.1-3
VMTS is characterized by incomplete separation of the posterior vitreous with persistent macular attachment. Vitreomacular adhesions and VMTS both involve posterior hyaloid attachments to the retina. However, in VMTS, the presence of traction causes structural damage or change. Typically, vitreomacular adhesion does not cause any structural damage (Figure 1). VMTS can be associated with ERM/foveal cavitation/cystoid macular edema/lamellar hole/pseudohole. VMTS could be focal or broad.4
Before the development of optical coherence tomography, ultrasonography and slit-lamp biomicroscopy were the primary tools for the diagnosis of VMTS. With advanced spectral-domain OCT, the understanding of VMA has improved extensively. Improved resolution, faster scanning speed, registration and eye tracking provide unparalleled information about VMA.

Figure 1. SD-OCT scans showing the difference between vitreomacular adhesion and vitreomacular traction.
Top image shows attachment of posterior hyaloid (arrow) without any distortion of normal foveal contour suggestive of vitreomacular adhesion; this is a very normal configuration in older eyes.
Bottom image shows posterior hyaloid (arrow) with distortion of foveal contour with cystic changes and splitting of retina suggestive of vitreomacular traction.
In our practice, we use a Heidelberg Spectralis, which provides real-time simultaneous scanning laser ophthalmoscopy (SLO) images of the retina.
SD-OCT IN THE MANAGEMENT OF VMA
There are many advantages of SD-OCT in the management of VMA. These include:
Normal variation in vitreomacular relationship. Spectralis SLO/SD-OCT and some other SD-OCT instruments allow for visualization of precortical vitreous, as well as the normal vitreoretinal relationship.
Use of raster scans. Focal areas of VMAs can be missed by standard horizontal and vertical scans through the fovea. Raster scanning patterns help to diagnose and determine the extent of the VMAs to plan for vitreoretinal surgery. One can perform a maximum of 651 scans at 11 µm apart, from arcade to arcade, to delineate the full ana tomy of the macula in relationship to the vitreous. Figures 2 and 3 show the various patterns of vitreomacular tractions in the same eye. Preoperative knowledge of these adhesions helps to plan the intraoperative steps.

Figure 2. Horizontal raster SD-OCT scans in an eye with vitreomacular traction.
Top: scan through fovea showing a lamellar hole and posterior hyaloid with attachment nasally causing retinal traction.
Middle: Scan below the fovea showing attachment of posterior hyaloid with increased retinal thickness.
Bottom: Scan below the fovea showing posterior hyaloid with retinal traction causing plication (areas of loose adhesions between posterior hyaloid and retina). Raster scans give important information about the extent of traction and are helpful in surgical planning.
Figure 3. Vertical raster SD-OCT scans of the same eye as in Figure 2 showing posterior hyaloid causing vitreomacular traction with plication. Area of haze above and below the posterior hyaloid is artifact and does not represent vitreous gel.
Analysis of ERM. We have shown that the knowledge of the extent of epiretinal membrane and ERM-retinal interface adhesions is useful to planning surgery and predicting any surgical difficulties. In our experience, the presence of fibrillary changes (Figure 4) of the retinal nerve fiber layer cause more surgical difficulty, as these changes could be a sign of a strong adhesion between the ERM and the macular tissue.5

Figure 4. SD-OCT scan through fovea showing epiretinal membrane with plications (arrow). In our experience, removal of ERM over the areas of plication is easier due to loose adhesions. Areas without plication are more difficult to peel. Preoperative knowledge of grade and type of adhesion helps to plan for ERM removal.
Diagnosis of posterior vitreous detachment. SD-OCT provides information, not only about the vitreoretinal interface, but also about the presence of complete or partial PVD.6 Knowledge of PVD helps in treatment planning. For example, in an eye with a symptomatic lattice, no laser is needed if a complete PVD is present. Indeed, vitreous adhesion and traction on the lattice and retinal tears can be seen, using peripheral retinal scans on the Spectralis or other instruments that simultaneously perform retinal imaging and OCT.
The presence of a Weiss ring clinically confirms the complete PVD. However, on occasion, a Weiss ring may not be seen clinically, even on OCT, due to complete separation of the posterior hyaloid into the midvitreous cavity. In such cases, the focus of the SD-OCT can be moved anteriorly, and the Weiss ring often can be seen.
Ultrasonography also may be useful in confirming the presence of PVD. As seen in the top image of Figure 5, an SD-OCT scan focused on the retina/optic nerve head shows no vitreous attachment. The bottom image shows the posterior hyaloid on SD-OCT when the Weiss ring was focused.

Figure 5. Simultaneous SLO/SD-OCT scans of optic nerve head.
Top: Focus is on the optic disc/retina showing normal optic disc with no vitreous attachment on the optic nerve head margins. Weiss ring is seen in infrared image.
Bottom: Focus moved anteriorly on the Weiss ring, showing detached posterior hyaloid on SD-OCT scan. Determination of complete PVD is important for making decisions for laser for symptomatic lattice degeneration and may also be useful in planning certain types of surgical procedures.
Serial progression raster scans at the same ana tomical site. Spectralis has the ability to colocalize follow-up scans in precisely the same location as the baseline scan. The colocalization ability is very helpful in assessing the patient's response to treatment, especially in eyes with AMD/DME/ERM (Figure 6).

Figure 6. Preoperative (top) and postoperative (bottom) serial progression SD-OCT scans at the same anatomical site. Patient presented with best corrected visual acuity of 20/60 with posterior hyaloid (arrow-head) causing traction, epiretinal membrane and outer retinal damage (arrow) on SD-OCT scan (top). Patient underwent vitrectomy with ERM removal and recovered visual acuity improved to 20/50.
Postoperative scan (bottom) showed normal foveal contour with persistent outer retinal damage (arrow). Reason for limited visual improvement in our patient despite complete recovery of foveal contour was the pre-existing outer retinal damage.
Preoperative evaluation of outer retinal structures (inner segment/outer segment junction and external limiting membrane) is important to predict visual outcome in eyes with ERM removal.
Analysis of outer retinal structures. Visualization of outer retinal structures is very difficult using time-domain OCT, due to its low resolution and slow speed. SD-OCT provides excellent visualization of the inner-segment (IS/OS) junction and external limiting membrane (ELM). We have shown that these photoreceptor structures are often the strongest predictors of vision.
Interestingly, older literature using TD-OCT showed only a modest relationship between retinal thickness and visual acuity in DME.7-10 Among others, we have shown a stronger association of outer retinal structures—including the IS/OS junction and ELM—with visual acuity, compared to central macular thickness, in eyes with VMT/ERM/macular hole/retinal detachment/DME.8,11-15
ASSESSMENT TECHNIQUE
In order to assess the outer retinal structures, we recommend a technique that allows analysis of the photoreceptor IS/OS junction or ELM on horizontal and vertical scans, for 500 µm in either direction of the fovea. The IS/OS disruption can be graded as being intact, focally disrupted, or extensively disrupted when looking at both horizontal and vertical scans through the fovea or when combined to yield a global disruption scale. Scans can also be quantified to yield a percentage of damage to the IS/OS junction or ELM (Figure 7).
Figure 7. Grading of outer retinal structure damage.
Top: SD-OCT scan of an eye with DME showing the presence of epiretinal membrane with retinal edema. Inner segment/outer segment junction (arrow) and ELM (arrowhead) are intact in central 1000 microns, ie, 0% disruption.
Middle: SD-OCT scan of an eye with diabetic macular edema showing presence of epiretinal membrane with cystic changes at fovea. Forty percent of IS/OS junction (arrow) and ELM (arrow-head) is disrupted in central 1000 microns.
Bottom: SD-OCT scan of an eye with choroidal neovascularization secondary to age related macular degeneration showing presence of vitreomacular adhesion, cystic fovea and the neovascular membrane subfoveally. Outer retinal structures are completely disrupted (100% damage) in the subfoveal area.
Percentage damage of outer retinal structures would be helpful to predict the visual outcome.
Preop knowledge of outer retinal integrity with highresolution SD-OCT, as well as knowledge of the extent of outer retinal structure disruption, is helpful in predicting visual outcomes in certain macular diseases. Figure 4 shows outer retinal damage in an eye with ERM during a preop scan. This patient underwent ERM removal and achieved a normal foveal contour; however, his vision only improved to 20/50 from 20/60 due to outer retinal damage (Figure 6).
Presence of ERM/traction also contributes to DME (Figure 8). Eyes with tractional edema may not respond to nonsurgical treatment options, such as laser photocoagulation, anti-VEGF drugs, or intravitreal steroids. Pars plana vitrectomy, with removal of ERM, may be recommended in such cases. Removal of ERM may lead to recovery of foveal contour with visual improvement.

Figure 8. SD-OCT scan through fovea in an eye with DME showing epiretinal membrane with cystic spaces/intraretinal fluid. Inner-segment/outer segment junction (arrow) and external limiting membrane (arrow-head) appears intact in subfoveal area, which predicts a better visual outcome.
In the past, central macular thickness, and pretreatment visual acuity were proposed to be the best predictors for visual recovery in DME eyes.9,10 However, in our experience with improved visualization of outer retinal structures on SD-OCT, there is a stronger correlation of the IS/OS junction and ELM with visual acuity in DME eyes, compared to CMT or pretreatment visual acuity.12
The role of VMA in exudative, as well as non-exudative, AMD is controversial. Persistent attachment of the posterior vitreous cortex to the macula may be a factor reducing anti-VEGF response in exudative AMD via vitreoretinal traction inducing chronic low-grade inflammation, by maintaining macular exposure to cytokines or free radicals in the vitreous gel, or by interfering in transvitreous oxygenation and nutrition of the macula.
Recently, we and others showed that outer retinal structures, including the IS/OS and ELM, correlate with visual acuity in these eyes and may predict surgical outcomes.1,2 Although the roles of VMT and ERM as predictors of visual outcomes in eyes with wet AMD are not well understood, their presence may be responsible for resistance to anti-VEGF therapy. Surgical intervention, with removal of VMT or ERM, may result in improvement of vision or the response to anti-VEGF therapy. In cases with significant outer retinal damage, vitrectomy may achieve the resolution of CME, but the visual improvement may not be proportional (Figure 9).

Figure 9. Top: SD-OCT scan shows cystic retina with vitreomacular traction with underlying choroidal neovascularization complex. Patient underwent vitrectomy with removal of the traction. Monthly intravitreal bevacizumab was continued.
At six months follow-up (bottom), SD-OCT shows complete re-absorption of intraretinal fluid with normal foveal contour. Vision improved from 20/400 to 20/320. Outer retinal damage with the thick scar tissue is the cause of poor visual outcome.
SUMMARY
In conclusion, eyes with VMA benefit from surgery. The visual prognosis is better, depending upon the extent of outer retinal structural damage. Central macular thickness may not be a good predictor of visual outcome. Rather, the integrity of the outer retinal structures, including the IS/OS junction and the ELM, on SD-OCT are the better predictors for visual outcome.
Incorporating high-quality SD-OCT in clinical practice is extremely helpful in the management of eyes with VMAs and is also useful in eyes with DME and choroidal neovascularization. RP
REFERENCES
1. Krebs I, Brannath W, Glittenberg C, Zeiler F, Sebag J, Binder S. Posterior vitreo macular adhesion: a potential risk factor for exudative age-related macular degeneration? Am J Ophthalmol. Nov 2007;144(5):741-746.
2. Mojana F, Cheng L, Bartsch DU, et al. The role of abnormal vitreomacular adhesion in age-related macular degeneration: spectral optical coherence tomography and surgical results. Am J Ophthalmol. Aug 2008;146(2):218-227.
3. Pendergast SD. Vitrectomy for diabetic macular edema associated with a taut premacular posterior hyaloid. Curr Opin Ophthalmol. Jun 1998;9(3):71-75.
4. Koizumi H, Spaide RF, Fisher YL, Freund KB, Klancnik JM, Jr., Yannuzzi LA. Threedimensional evaluation of vitreomacular traction and epiretinal membrane using spectral-domain optical coherence tomography. Am J Ophthalmol. Mar 2008;145(3):509-517.
5. Freeman WR KJ, Chhablani J, Hartmann K, Cheng LC. Predictive Value of SD
OCT Morphology on Surgical Findings in Macular Pucker. ARVO 2011. Fort Lauderadale2011.
6. Mojana F, Kozak I, Oster SF, et al. Observations by spectral-domain optical coherence tomography combined with simultaneous scanning laser ophthalmoscopy: imaging of the vitreous. Am J Ophthalmol. Apr 2010;149(4):641-650.
7. Shah SP, Patel M, Thomas D, Aldington S, Laidlaw DA. Factors predicting outcome of vitrectomy for diabetic macular oedema: results of a prospective study. Br J Ophthalmol. Jan 2006;90(1):33-36.
8. Wakabayashi T, Oshima Y, Fujimoto H, et al. Foveal microstructure and visual acuity after retinal detachment repair: imaging analysis by Fourier-domain optical coherence tomography. Ophthalmology. Mar 2009;116(3):519-528.
9. Blumenkranz MS, Haller JA, Kuppermann BD, et al. Correlation of visual acuity and macular thickness measured by optical coherence tomography in patients with persistent macular edema. Retina. Jul-Aug 2010;30(7):1090-1094.
10. Browning DJ, Glassman AR, Aiello LP, et al. Relationship between optical coherence tomography-measured central retinal thickness and visual acuity in diabetic macular edema. Ophthalmology. Mar 2007;114(3):525-536.
11. Oster SF, Mojana F, Brar M, Yuson RM, Cheng L, Freeman WR. Disruption of the photoreceptor inner segment/outer segment layer on spectral domain-optical coherence tomography is a predictor of poor visual acuity in patients with epiretinal membranes. Retina. May 2010;30(5):713-718.
12. Maheshwary AS, Oster SF, Yuson RM, Cheng L, Mojana F, Freeman WR. The association between percent disruption of the photoreceptor inner segment-outer segment junction and visual acuity in diabetic macular edema. Am J Ophthalmol. Jul 2010;150(1):63-67 e61.
13. Otani T, Yamaguchi Y, Kishi S. Correlation between visual acuity and foveal microstructural changes in diabetic macular edema. Retina. May 2010; 30(5):774-780.
14. Oishi A, Hata M, Shimozono M, Mandai M, Nishida A, Kurimoto Y. The significance of external limiting membrane status for visual acuity in age-related macular degeneration. Am J Ophthalmol. Jul 2010;150(1):27-32 e21.
15. Theodossiadis PG, Grigoropoulos VG, Theodossiadis GP. The significance of the external limiting membrane in the recovery of photoreceptor layer after successful macular hole closure: a study by spectral domain optical coherence tomography. Ophthalmologica. 2011;225(3):176-184.
| Jay Chhablani, MD, is associate professor of ophthalmology at the Muthusamy Virtual University of Postgraduate Ophthalmology. William R. Freeman, MD, is professor and director of the Jacobs Retina Center at the University of California-San Diego's Shiley Eye Center in La Jolla, CA. Dr. Chhablani reports no financial interest in any products mentioned in this article. Dr. Freeman reports minimal financial interest in OD-OS, Heidelberg and Canon. Dr. Freeman can be reached via e-mail at wrfreeman@ucsd.edu. |








